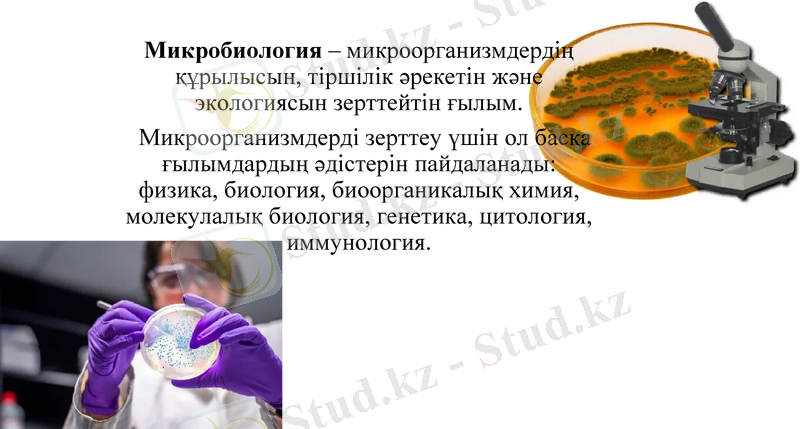
Slide 3

Стандартты микробиологиялық зертхана: құрылымы, негізгі жұмыс әдістері және тағам өнімдерін бақылау



Стандартты микробиологиялық зертхана. Жұмыс істеудің негізгі әдістері. Тағамдық өнімдерді бақылау зертханаларының сипаттамасы.
Дайындаған: Әлиева Ләззат
Болат Қуаныш
Садықова Нұргүл
Сырымова Мадина
Турғанбаев Бақдәулет
Қабылдаған: Матеева Ақмарал

Жоспар:
Кіріспе
Негізгі бөлім Микробиологиялық зертхана құрылымы Зертханада қолданылатын құрал-жабдықтар Зертханада жұмыс істеудегі негізгі әдістер Тағамдық өнімдерді бақылау
Қорытынды
Микробиология - микроорганизмдердің құрылысын, тіршілік әрекетін және экологиясын зерттейтін ғылым.
Микроорганизмдерді зерттеу үшін ол басқа ғылымдардың әдістерін пайдаланады: физика, биология, биоорганикалық химия, молекулалық биология, генетика, цитология, иммунология.

Микробиологиялық зертхана
Микробиологиялық зертхана - ғылыми-зерттеу зертханалық жұмыстарды орындауға бағытталған мамандандырылған кәсіптік ұйым. Мақсатына қарай микробиологиялық зертханалар бактериологиялық, паразитологиялық, микологиялық, вирусологиялық, иммунологиялық және арнайы (ерекше қауіпті инфекцияларды диагностикалау үшін) болуы мүмкін.

МИКРОБИОЛОГИЯЛЫҚ ЗЕРТХАНАЛАРДЫҢ НОМЕНКЛАТУРАСЫ
Жалпы не арнайы типтегі клиникалық-диагностикалық лаб-р
Бактериологиялық лаб
Арнайы лаб-р (өте жұқпалы инфекцияларға)
Санитарлы-химиялық лаб
Санитарлы-бактериологиялық лаб

Зертханалардың негізгі зерттеу қызметі
Жедел диагностика
Коагулологиялық
Биохимиялық
Жалпы клиникалық
Иммунологиялық
Гематологиялық
Цитологиялық
Молекулалық-биологиялық
Микробиологиялық Зертхана
Орталықтандырылған Клиникалық-Диагностикалық Зертхана (ЦКДЛ)
Санитарлық
Микрофлораны зерттеу
Тамшылы инфекциялар
Ішек инфекциясы

Кез-келген бактериологиялық зертхананың құрылымына мыналар кіреді
асептикалық жағдайда жұмыс істеуге арналған зертханалық бөлмелер немесе бокстар;
қоректік ортаны дайындауға арналған бөлме;

Кез-келген бактериологиялық зертхананың құрылымына мыналар кіреді
қоректік орталарды, ыдыстарды зарарсыздандыруға, пайдаланылған жұқтырған материалды зарарсыздандыруға арналған арнайы жабдықталған орындар;

III және IV топтардың патогендік биологиялық агенттерімен ( ПБА ) жұмыс істейтін зертханалар жеке ғимаратта немесе ғимараттың оқшауланған бөлігінде орналасуы керек.
Олардың екі есігі болуы керек:
біреуі қызметкерлер үшін;
екіншісі зерттеу үшін материалды жеткізу үшін.




Стерилизация - бұл микробтар тіршілігінің барлық нысандарын, соның ішінде вегетативті жасушаларды, спораларды және вирустарды беткейден, ортадан немесе заттардан жою немесе физикалық түрде жою процесі.
Микроорганизмдерді бақылаудың негізгі себептері:
Стерилизация
Жұмыс істеудің негізгі әдістері.

Химиялық агенттердің негізгі тобы:
фенол және фенол қосылыстары,
спирттер,
ауыр металдар және олардың қосылыстары,
бояғыштар,
сабын және жуғыш заттар,
альдегидтер,
газ тәрізді заттар
а) Иондаушы емес сәулелену
Ультракүлгін сәулелену
Инфрақызыл сәулелену
б) Иондаушы сәулелену
Рентген сәулелері
Гамма сәулелері
Жұмыс істеудің негізгі әдістері.

Жұмыс істеудің негізгі әдістері.

Тағамдық өнімдерді бақылау зертханаларының сипаттамасы
Зертханада сынау ғылыми талдау арқылы азық-түлік проблемаларын диагностикалаудың маңызды буыны болып табылады. Тестілеу қолданыстағы сапаны бақылау жүйесі шеңберінде өнімнің немесе процестің сапасы туралы аналитикалық деректерді алуға көмектеседі, сондай-ақ өнімдерді өндіру тұтынушылардың өмірі мен денсаулығы үшін қауіпсіз екендігіне сенімді дәлелдер береді.

Тамақ өнімдерін зертханалық тексеру әдістері

Азық-түлік зертханаларында сынау үшін бірнеше түрлі аспаптар мен жүйелер қолданылады. Тағамдық талдаудың орталық бөлігі болып спектрометрлер, алкоголь өлшегіштер, рефрактометрлер, титраторлар, ылғал анализаторлар және басқа да стандартты зертханалық жабдықтар табылады.
Тамақ зертханасы сонымен қатар сынау үшін индуктивті байланысқан плазмалық масс-спектрометрияны, газ хроматографиясын және жоғары қысымды сұйықтық хроматографиясын пайдаланады.
Бірқатар әдістер мен қолданбалар үшін арнайы анализаторлар мен есептегіштер қолданылады.

Қорытынды:
Микробиологияда қолданылатын әдістердің көмегімен адамдар кейбір жұқпалы аурулардың әртүрлі қоздырғыштарын анықтауды және анықтауды үйренді. Дұрыс таңдалған әдіс болашақта ауруларды дұрыс емдеуге ықпал етеді.
- Іс жүргізу
- Автоматтандыру, Техника
- Алғашқы әскери дайындық
- Астрономия
- Ауыл шаруашылығы
- Банк ісі
- Бизнесті бағалау
- Биология
- Бухгалтерлік іс
- Валеология
- Ветеринария
- География
- Геология, Геофизика, Геодезия
- Дін
- Ет, сүт, шарап өнімдері
- Жалпы тарих
- Жер кадастрі, Жылжымайтын мүлік
- Журналистика
- Информатика
- Кеден ісі
- Маркетинг
- Математика, Геометрия
- Медицина
- Мемлекеттік басқару
- Менеджмент
- Мұнай, Газ
- Мұрағат ісі
- Мәдениеттану
- ОБЖ (Основы безопасности жизнедеятельности)
- Педагогика
- Полиграфия
- Психология
- Салық
- Саясаттану
- Сақтандыру
- Сертификаттау, стандарттау
- Социология, Демография
- Спорт
- Статистика
- Тілтану, Филология
- Тарихи тұлғалар
- Тау-кен ісі
- Транспорт
- Туризм
- Физика
- Философия
- Халықаралық қатынастар
- Химия
- Экология, Қоршаған ортаны қорғау
- Экономика
- Экономикалық география
- Электротехника
- Қазақстан тарихы
- Қаржы
- Құрылыс
- Құқық, Криминалистика
- Әдебиет
- Өнер, музыка
- Өнеркәсіп, Өндіріс
Қазақ тілінде жазылған рефераттар, курстық жұмыстар, дипломдық жұмыстар бойынша біздің қор #1 болып табылады.



Ақпарат
Қосымша
Email: info@stud.kz